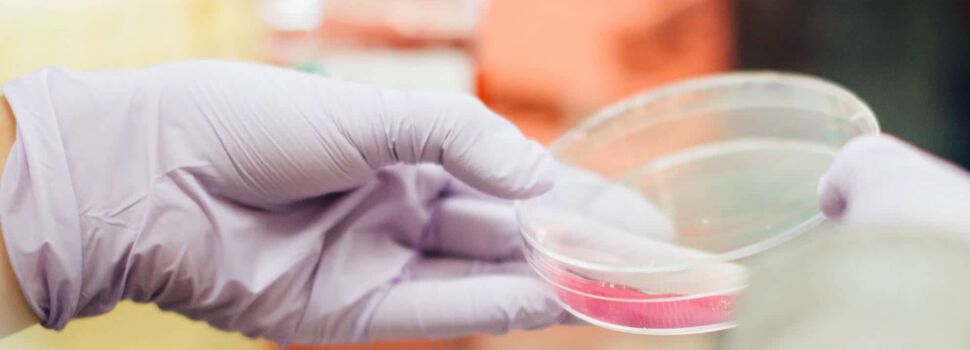

Gengive: scoperte le cellule sentinella!
Si deve all’italiano Marco Tizzano, originario della provincia di Verona e oggi ricercatore presso il Monell Chemical Senses Center a Philadelphia, la scoperta relativa alla presenza di alcune cellule “sentinella” presenti nelle nostre gengive ed aventi un ruolo fondamentale per la loro salute.
Resa nota sulla rivista Nature Communications, la ricerca mostra come queste “cellule chemosensoriali solitarie” siano in grado di avvertire il gusto amaro che spesso si associa alla presenza di batteri patogeni pericolosi per il cavo orale. Attivate da questa “spia” amara, le sentinelle gengivali stimolano il rilascio di molecole antimicrobiche che proteggono le gengive dai patogeni, contribuendo a ripristinare il corretto equilibrio dei batteri (microbiota) del cavo orale. Grazie a queste cellule è possibile quindi ristabilire le corrette proporzioni tra i differenti microrganismi presenti in bocca.
La scoperta dell’esistenza di queste cellule sentinella fornisce nuovi spunti a tutti gli studiosi ed esperti di parodontite. La parodontite è una patologia che colpisce proprio le gengive ed è causata da un’infezione batterica che, se trascurata, può anche condurre alla caduta dei denti.
Secondo la scienza, dunque, il nostro stesso organismo sarebbe in grado di riconoscere i batteri responsabili delle infezioni che conducono a problemi gengivali e riuscirebbe ad innescare una risposta immunitaria proprio per combattere e debellare la patologia.
Fonte: Repubblica.it